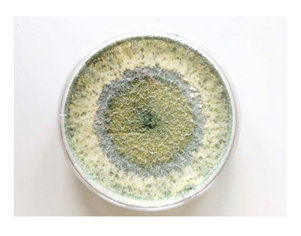
Eine Petrischale mit deutlichem kreisförmigen Pilzaufwuchs

- Home
- Forschung
- Forschungszentren
- Hydrologische Forschungsstation Siptenfelde
- Kompetenzzentrum Frühe Bildung
- Kompetenzzentrum Inklusive Bildung Sachsen-Anhalt
- Industrielabor Innovative Fertigungsverfahren
- Institut für Wasserwirtschaft und Ökotechnologie
- Institut für Gesundheitsförderung und Prävention in Lebenswelten
- Institut für demokratische Kultur
- An-Institute der Hochschule
- Institut für Wasserwirtschaft und Ökotechnologie

Herzlich willkommen auf der IWO-Seite
Das Institut für Wasserwirtschaft und Ökotechnologie (IWO), gegründet im Januar 1994, dient der Hochschule als wissenschaftliche Einrichtung des Fachbereichs Wasser, Umwelt, Bau und Sicherheit. Dabei steht die Bearbeitung von praxisorientierten Forschungsthemen in weiten Bereichen der Wasserwirtschaft und des Recycling und Entsorgungsmanagements im Mittelpunkt. Mit der Gründung des Instituts wurde die Möglichkeit geschaffen, Studierende in vielfältiger Form in die Forschungsaktivitäten zu integrieren. Der Schwerpunkt der Arbeit des Instituts liegt in der Verzahnung von angewandter Forschung und Lehre.
Wasser- und Abfallwirtschaft (WAwi) im Dialog | 29. April 2026
Am 29. April findet die nächste Veranstaltung der Reihe "Wasser- und Abfallwirtschaft im Dialog" statt.
Dieses Mal begrüßt Sie das Fachgebiet Siedlungswasserwirtschaft, Schwerpunkt Abwasser mit dem Thema: Energiequelle Abwasser. Es werden Projekte und Maßnahmen zur Energieneutralität in der Siedlungswasserwirtschaft vorgestellt. Die einzelnen Inhalte und den zeitlichen Ablauf finden Sie hier im Flyer.
Die Teilnahme ist online oder in Präsenz möglich.
Anmeldung: hier
Anmeldeschluss ist der 28. April 2026
Für die Online-Teilnehmer wird der Zugangslink (ZOOM) wenige Tag vor der Veranstaltung versendet.
Forschung
Der Schwerpunkt der Arbeit des Instituts liegt in der Verzahnung von angewandter Forschung und Lehre. Die Fokussierung auf praxisorientierte Forschungsaufgaben steht im Mittelpunkt der Projekte der Wasser- und Kreislaufwirtschaft.
Fachgebiet Hochwasserrisikomanagement
Die intensiven Niederschlagsereignisse Mitte Juli 2021 über weiten Teilen Westeuropas und die damit verbundenen Hochwasserereignisse führten zu mehr als 200 Toten, zahlreichen Ausfällen von kritischen Infrastrukturen (KRITIS), ökonomischen Schäden im zweistelligen Milliardenbereich und noch unbezifferten psychosozialen Folgen bei Betroffenen sowie einschneidende ökologische Konsequenzen. Es wurde auf tragische Weise deutlich, dass sowohl für den vorbeugenden als auch für den operativen Hochwasserschutz mehr getan werden muss.
Dazu möchten wir mit unserer Forschungsarbeit beitragen. Unser vorrangiges Ziel ist es, Verfahren und Werkzeuge zu entwickeln, die ein nachhaltiges Hochwasserrisikomanagement unterstützen. Hydrologie, Statistik, Hydrodynamik, Konsequenzen für Ökonomie, kritische Infrastrukturen, Ökologie und Menschen, Zuverlässigkeit von Bauwerken und das Risiko selbst gilt es dabei, in ganzheitliche Ansätze und Werkzeuge zu integrieren
Weitere Informationen zur Arbeit der Arbeitsgruppe Hochwasserrisikomanagement (AG FRM) finden sie hier Informationen zur Arbeitsgruppe Hochwasserrisikomanagment.
Kontakt:
Fachgebiet Hydrologie und Geoinformatik
Das Fachgebiet Hydrologie und Geoinformatik beschäftigt sich mit folgenden Forschungsschwerpunkten:
- Messtechnische Erfassung der wichtigsten Wasserhaushaltskomponenten (Niederschlag, Abfluss, Grundwasser & Verdunstung)
- Hydrologische Vorhersagen & Prognosen
- Wasser- und Stofftransportprozesse in unterschiedlichen Skaleneinheiten der Landschaft quantitativ & qualitativ zu bewerten.
Kontakt:
Fachgebiet Gewässer- und Renaturierungsökologie
Das Fachgebiet Gewässer- und Renaturierungsökologie beschäftigt sich im Rahmen der Forschung mit folgenden Schwerpunkten:
· Ökologie und Lebensraumnutzung aquatischer Organismen, insbesondere von Fischen, in Gewässerökosystemen
· Auswirkungen zentraler ökologischer Herausforderungen – wie Klimawandel, hydromorphologische Veränderungen und invasive Arten – auf Lebensgemeinschaften in anthropogen geprägten Gewässern
· Gewässertypspezifische Bewertung von Gewässern im Rahmen der EU-Wasserrahmenrichtlinie
· Bewertung und Managementmaßnahmen im Kontext von Gewässerrenaturierung und der Wiederherstellung der Durchgängigkeit
· Inter- und transdisziplinäre Forschung zu Wechselwirkungen zwischen ökologischen Prozessen und menschlicher Nutzung in der Gewässerbewirtschaftung
· Räumlich-explizite und modellgestützte Analysen von Artenverbreitung, Habitatnutzung und Ausbreitungsdynamiken
Kontakt:
- Prof. Dr. Radinger
- Dr. Uta Langheinrich

Links: Sedimentationsröhre und Absetzkammer nach Utermöhl, Mitte: Inversionsmikroskop zur Auswertung der Absetzkammer
Rechts: mikroskopisches Bild einer abgesetzten, mit Lugols-Lösung gefärbten Planktonprobe mit verschiedenen Grün-, Kiesel,-Blau- und Jochalgen, Copyrights: Uta Langheinrich
Fachgebiet Ingenieurökologie
Arbeitsgruppe Ingnieurökologie
Die Arbeitsgruppe Ingenieurökologie beschäftigt sich im Rahmen der Forschung mit folgenden Schwerpunkten:
- Grüne Infrastruktur und Ökosystemleistungen
- Integriertes Ressourcenmanagement
- Ökosystemanalyse und Ökobilanzierung
Themenfokus:
- Stadtklima und Wasserhaushalt, Klimaanpassung
- Umwelt und Gesundheid
- Moorwiedervernässung
Wissenschaftliche Leitung:
Die Webseite unserer Arbeitsgruppe finden Sie hier: Arbeitsgruppe Ingenieurökologie an der Hochschule Magdeburg-Stendal.
Fachgebiet Internationale Wasserwirtschaft

Das Fachgebiet Internationale Wasserwirtschaft ist im Rahmen der Forschung mit folgenden Schwerpunkten beschäftigt:
- Water-Energy-Food Nexus, Water-Soil-Waste Nexus
- Grenzüberschreitende Wasserwirtschaft und Lösung internationaler Ressourcenkonflikte
- Sozioökonomie und Partizipation
- Länderfokus:
- Vietnam (Wasser und mineralische Ressourcen)
- Bangladesh (Meeresschutz und Fischressourcen), mehr Infos hier
- Ecuador (Wasser und Biodiversität)
- Südafrika, Spanien (bergbauliche Wasserwirtschaft)
Details zu den Forschungsaktivitäten im Themenfeld Internationale Wasserwirtschaft finden sich hier:
Wissenschaftliche Leitung:
Mitarbeiter:
- Tino Fauk, MSc, tino.fauk@h2.de
- Dipl.-Biochem. Conrad Dorer, conrad.dorer@h2.de
Die Webseite unserer Arbeitsgruppe finden Sie hier.
Details zu den Forschungsaktivitäten im Themenfeld Interationale Wasserwirtschaft finden Sie hier
Fachgebiet Ressourcenwirtschaft
Das Fachgebiet Ressourcenwirtschaft beschäftigt sich u.a. mit folgenden Forschungsschwerpunkten:
- Platinbestimmung von Membran-Elektroden-Einheiten aus Brennstoffzellen: Die genaue Kenntnis der Platingehalte von Membranen aus Brennstoffzellen ist für einen Aufbereitungsprozess und vor allem zur genauen Berechnung der Wertschöpfung von großer Bedeutung. Auf Grund der chemischen Zusammensetzung, vor allem durch erhöhte Fluorfrachten, wird die genaue Analytik, aber auch die Aufbereitung, erschwert. Im Mittelpunkt des Forschungsprojektes steht die Prüfung von Probenahme, Probeaufbereitung und Analytik hinsichtlich ihrer Eignung bei der Bestimmung von Platingehalten der Membran- Elektroden Einheiten.
- Mikrowellen-assistierte Aufbereitung lignocellulosehaltiger Reststoffe zur Erhöhung der Fermentierbarkeit: Ein wesentlicher Verfahrensschritt für die Nutzung lignocellulosehaltiger Reststoff, wie beispielhaft Stroh für fermentative Prozesse ist der Substrataufschluss. Ziel ist es dabei die Zellulose-Kristalinität zu senken, den Lignin Gehalt zu reduzieren und den Faserverbund zur Verbesserung der enzymatischen Zugänglichkeit zu lockern. In dem Forschungsprojekt wird die Eignung mikrowellen- assistierter katalytischer Substrataufschlüsse betrachtet.
- Recycling von carbonfaserverstärkten Kunststoffen: Ein Ansatz zur Effizienzsteigerung vieler Systeme liegt in der Substitution klassischer Konstruktionsmaterialien durch carbonfaserverstärkte Kunststoffe. Hier sei beispielhaft der Flugzeugbau und der Automotive Bereich genannt in dem diese Werksstoffe bereits heute schon vermehrt zum Einsatz kommen. Aber auch diese Produkte stehen in absehbarer Zeit zur Entsorgung an. Stoffliche Verwertungsverfahren zur Rückgewinnung der teuren Fasern existieren bis auf pyrolytische Ansätze nicht. Diese sind aber unter verschiedenen Gesichtspunkten als nicht optimal zu sehen. Im Mittelpunkt des Forschungsprojektes steht deshalb die Untersuchung geeigneter Alternativen zur stofflichen Rückgewinnung der Fasern.
Hier gelangen Sie zur Webseite der Arbeitsgruppe Rohstoffwerkstatt
Kontakt:
Abfallaufbereitungstechnik und Luftreinhaltung
Die Arbeitsgruppe Abfallaufbereitungstechnik und Luftreinhaltung entwickelt praxisnahe Lösungen für einen nachhaltigen Umgang mit Rest- und Abfallstoffen. Sie verbindet anwendungsorientierte Forschung mit Lehre und befasst sich mit Themen aus den Bereichen Kreislaufwirtschaft, Ressourceneffizienz und Emissionsminderung.
Schwerpunkte der Arbeitsgruppe:
- Biologische und thermische Abfallbehandlung
- Reststoffaufbereitung und Kreislaufwirtschaft
- Luftreinhaltung und Immissionsschutz
- Emissionsminderung in Landwirtschaft und Abfallwirtschaft
- Entwicklung torffreier und klimafreundlicher Substrate
- Nährstoffrückgewinnung und nachhaltige Düngemittel
- Prozessüberwachung und Qualitätssicherung in der Kompostierung
Kontakt:
Prof. Dr.-Ing. Carsten Cuhls, carsten.cuhls@h2.de
Besuchen Sie unsere Webseite der Arbeitsgruppe mit weiterführenden Informationen:
Arbeitsgruppe Abfallaufbereitungstechnik und Luftreinhaltung
Fachgebiet Siedlungswasserwirtschaft, Schwerpunkt Abwasser
Das Fachgebiet Siedlungswasserwirtschaft Schwerpunkt Abwasser betreibt in den unterschiedlichsten abwassertechnischen Bereichen sowie im Bereich Biogas anwendungsbezogene Forschung. Im Einzelnen wären da folgende Bereiche:
- Abwasser-/Schlammbehandlung: Simulation und verfahrenstechnische Optimierung von Prozessen; Machbarkeitsstudien; Zustandsanalysen und Konzepte zur Vermeidung von Betriebsproblemen; Steigerung der Energieeffizienz; spezielle Belüftungs-MSR-Konzepte; Test von Zusatzstoffen und Überwachung von Kläranlagen;
- Biogas: Modellierung und Simulation, verfahrenstechnische Optimierung von Anlagen; Machbarkeitsstudien; Steigerung der Ressourceneffizienz, Konzepte zur Gärrestaufbereitung, -behandlung und -verwertung.
Kontakt:
Hier gelangen Sie zur Webseite der Arbeitsgruppe Siedlungswasserwirtschaft Schwerpunkt Abwasser
Fachgebiet Siedlungswasserwirtschaft, Infrastrukturentwicklung
Schwerpunkt des Fachgebietes Siedlungswasserwirtschaft und Infrastrukturentwicklung in Lehre, Forschung und Dienstleistung ist der Umgang mit Infrastrukturnetzen zur Ver- und Entsorgung im Bestand. Dazu gehören Zustandserfassung und -bewertung, Sanierungsmöglichkeiten, Netzmanagement und Netzanpassung unter sich ändernden Randbedingungen sowie ökonomische Betrachtungen, insbesondere für kommunale Trink- und Abwassernetze.
Die Schwerpunkte in Lehre und Forschung sind:
Nachhaltige Planung:
- Anpassung von Infrastrukturnetzen unter veränderten demographischen, klimatischen und strukturellen Randbedingungen
- Bewertung der Nachhaltigkeit von Infrastrukturbaumaßnahmen
- Langfristige Koordination städtebaulicher und stadttechnischer Maßnahmen
Netzmanagement:
- Modellierung des Alterungsverhaltens von Infrastrukturelementen
- Prognose des Erneuerungsbedarfs für Infrastrukturnetze
- Prognose der Restnutzungsdauer von Infrastrukturelementen
- Auswahl und Definition geeigneter Erneuerungsstrategien
Wirtschaftlichkeit:
- Tarifsysteme
- Substanzwertanalyse
- Wirtschaftlichkeit von Sanierungsalternativen
Forschungsprojekte:
- zum Projekt SubKanS: „Entwicklung eines Standards zur Bewertung und Klassifizierung der baulichen Substanz von Abwasserkanälen und Schächten“
- diverse Kleinprojekte in Kooperation mit Städtische Werke Magdeburg SWM und Trinkwasserversorgung Magdeburg TWM
Kontakt:
Fachgebiet Umwelt-Datenanalyse und statistische Modellierung
Das Fachgebiet Umwelt-Datenanalyse und statistische Modellierung beschäftigt sich in Forschung und Lehre u.a. mit den folgenden Schwerpunkten:
- Entwicklung und Anwendung neuer Methoden der linearen und nichtlinearen Zeitreihenanalyse auf Basis von Ansätzen aus den Bereichen der Angewandten Statistik, Komplexitätsforschung und des Maschinellen Lernens
- Durchführung von Zeitreihenanalysen im Bereich der Klimavariabilität in Vergangenheit, Gegenwart und Zukunft, u.a. zur Statistik und Dynamik klimatischer Extremereignisse sowie zu Kipp-Punkten im Klimasystem, im Kontext von Grundlagen- und anwendungsbezogenen Forschungsprojekten
- Durchführung von Zeitreihenanalysen in den Bereichen atmosphärische Elektrizität, Umweltradioaktivität und Weltraumwetter, inklusive eigenständiger Erhebung von Beobachtungszeitreihen
- Grundlagenausbildung für Studiengänge des Bau- und Umweltingenieurwesens in den Bereichen Mathematik, Statistik und Künstliche Intelligenz, inklusive der Entwicklung digitaler Lehr- und Lernmaterialien und hochschuldidaktischer Begleitforschung
Kontakt:
Fachgebiet Wasserbau und Wasserbauliches Versuchswesen
Im Fachgebiet Wasserbau werden Forschungsprojekte durchgeführt, um projektbezogene Fragestellungen aus der wasserbaulichen Praxis beantworten zu können. Die Forschungsschwerpunkte sind u.a.:
- Experimentelle Untersuchungen im Wasserbaulabor zu hydraulischen und morphologischen Prozessen in Fließgewässern, wie bspw. Wasserkraftanlagen, Wehranlagen- und Tosbeckendimensionierungen, Deichdichtungen, Sohlengleiten, Verlandungs- und Erosionsprozesse, Bauwerkskolke, Sedimenttransport u.a.
- Hydrodynamische Modellierung (1D, 2D, 3D) bspw. zu Deichbemessungen, Deichbruchsimulationen, Vorlandbewirtschaftung sowie Feststofftransportmodellierung
- Felduntersuchungen mit eigenen Messbooten und Ausstattung u.a. für Echolotpeilungen, Vermessungen, Geschiebe- und Suspensionsmessungen, Wasserspiegelmessungen.
Kontakt:

Hier gelangen Sie zur Webseite der Arbeitsgruppe Wasserbau und Wasserbauliches Versuchswesen.
2D-hydrodynamisch-numerische Berechnung des Hochwasserereignis 2013. Wassertiefen- und Fließvektorendarstellung.
Fachgebiet Wasserversorgung
Das Fachgebiet Wasserversorgung beschäftigt sich mit Problemstellungen in den Bereichen Trinkwasseraufbereitung, -transport und Ressourcenschutz. Projekt- und Forschungsschwerpunkte sind u.a.:
- Verfahrensoptimierung in Wasserwerken; Modellversuche zu Filtrations- und Rückspülprozessen und zum Einsatz alkalischer Filtermaterialien; Laborversuche zum Flockungsmitteleinsatz und -dosierung; Variantenbetrachtung Spülwasserverwertung, z.B. in der Ziegelindustrie, zur Phosphatbindung in Kläranlagen, in Biogasanlagen; Energieeffiziente Pumpenschaltungen
- Erfassung und Beschreibung von Partikelgehalten im Trinkwasserwerk sowie deren Verhalten im Verteilungsnetz
- Mischwasserberechnung und Bewertung des Korrosionsverhaltens
- Oberflächen- und Grundwassermonitoring.
Kontakt:
IWO-Schriftenreihe

Im Jahr 2005 wurde die Schriftenreihe des Instituts für Wasserwirtschaft und Ökotechnologie "Magdeburger Wasserwirtschaftliche Hefte" ins Leben gerufen. Bisher sind insgesamt 15 Bände erschienen:
Beiträge zum Institutskolloquium "Die Elbe im Spannungsfeld von Hochwasserschutz, Naturschutz & Schifffahrt"
| Band | Jahr | Titel |
|---|---|---|
| Bd. 1 | 2005 | Hochwassermanagement |
| Bd. 2 | 2005 | Vergleichende Untersuchung und kritische Einschätzung aktueller Methoden zur Bewertung von Oberflächengewässern gemäß den Vorgaben der EU-Wasserrahmenrichtlinie am Beispiel von Gewässern in Großschutzgebieten Sachsen-Anhalts |
| Bd. 3 | 2006 | Sustainable Approaches in Water Management, Urban Planning and Effective and Renewable Energy Uses, Indianapolis, September 16 and 17, 2005 |
| Bd. 4 | 2006 | Festschrift: 50 Jahre Wasserwirtschaftsausbildung in Magdeburg (1956 - 2006) |
| Bd. 5 | 2006 | Technische, ökologische und soziale Aspekte moderner Abwasserbehandlung |
| Bd. 6 | 2006 | Beiträge zur Konferenz "Strategien und Instrumente zur Verbesserung des vorbeugenden Hochwasserschutzes" |
| Bd. 7 | 2007 | Studie "Wettbewerbsfähige und lebenswerte Altmark – Daseinsvorsorge in einer ländlichen Region" |
| Bd. 8 | 2007 | Beiträge zum Institutskolloquium "Bewertung von Gewässern bei der Umsetzung der EU-Wasserrahmenrichtlinie" |
| Bd. 9 | 2008 | Schutz und Regeneration von Gewässerökosystemen und Wasserressourcen durch ingenieurökologische Methoden |
| Bd. 10 | 2010 | Beiträge zum Institutskolloquium "Auswirkungen von Eingriffen in Fließgewässern" |
| Bd. 11 | 2011 | Ressourcenbewirtschaftung im Siedlungsraum – Rahmenbedingungen neuartiger Sanitärsysteme im urbanen Umfeld |
| Bd. 12 | 2012 | Transformationsprozesse öffentlicher Daseinsvorsorge im ländlichen Raum – am Beispiel der Altmark |
| Bd. 13 | 2012 | Assessment of constructed wetlands in arid regions with special regard to ecology and multifunctionability |
| Bd. 14 | 2013 | Beiträge zum Institutskolloquium "Die Elbe im Spannungsfeld von Hochwasserschutz, Naturschutz & Schifffahrt |
| Bd. 15 | 2017 | Naturnaher Einsatz von Holz zur Entwicklung von Fließgewässern im Norddeutschen Tiefland |
Informationen zu den Autoren und zur Bestellnummer finden Sie hier:
Jahresberichte
Der Fokus des Instituts liegt in der Bündelung der verschiedensten Forschungsaktivitäten des Fachbereichs, wobei anwendungsorientierte und praxisbezogene regionale Aufgaben im Mittelpunkt der Arbeit standen. In Jahresberichten stellt das IWO die vielen Forschungsvorhaben vor:
Aktueller Jahresbericht 2024
Der IWO-Jahresbericht 2024 dokumentiert die Forschungsaktivitäten am Institut für Wasserwirtschaft und Ökotechnologie (IWO) als In-Institut des Fachbereiches Wasser, Umwelt, Bau und Sicherheit (WUBS) der Hochschule Magdeburg-Stendal für das Berichtsjahr 2024.
Auflistung vergangener Jahresberichte
Organisation
Die derzeitige Institutsleitung setzt sich aus dem Institutsdirektor und der wissenschaftlichen Leitung zusammen. Die Aufgaben des Institutsdirektors werden seit April 2022 von Prof. Dr.-Ing. habil. Jürgen Wiese wahrgenommen.

Institutsdirektor
Prof. Dr.-Ing. habil. Jürgen Wiese
Tel.: (0391) 886 43 73
E-Mail: juergen.wiese@h2.de
Besucheradresse: Haus 6, Raum 2.12
Fachgebiet: Siedlungswasserwirtschaft Schwerpunkt Abwasser

Wissenschaftliche Leitung
Prof. Dr.-Ing. Bernd Ettmer
Tel.: (0391) 2187 44 29
E-Mail: bernd.ettmer@h2.de
Besucheradresse: Haus 6, Raum 2.16
Fachgebiet: Wasserbau und Wasserbauliches Versuchswesen

Wissenschaftliche Leitung
Prof. Dr. rer. nat. Volker Lüderitz
Tel.: (0391) 886 43 67
E-Mail: volker.luederitz@h2.de
Besucheradresse: Haus 6, Raum 2.23
Fachgebiet: Hydrobiologie und Gewässerökologie

Wissenschaftliche Leitung
Prof. Dr. rer. nat. habil. Frido Reinstorf
Tel.: (0391) 886 44 80
E-Mail: frido.reinstorf@h2.de
Besucheradresse: Haus 6, Raum 2.26
Fachgebiet: Hydrologie und Geoinformatik

Wissenschaftliche Leitung
Prof. Dr.-Ing. Torsten Schmidt
Tel.: (0391) 886 46 79
E-Mail: torsten.schmidt@h2.de
Besucheradresse: Haus 6, Raum 2.16
Fachgebiet: Siedlungswasserwirtschaft und Infrastrukturentwicklung
Publikationen
Aktuelle Veröffentlichungen
Endbericht_Forschungsprojekt_Optiphos_MWU
Zur Revitalisierung des Großen Bruchs in Sachsen-Anhalt (August 2025)
Macroinvertebrate Community in Streams on the Canary Islands: Gradient Analysis and Stressors (2024)
Veröffentlichungen 2019 bis 2024
In diesem Bereich befinden sich alle Veröffentlichungen, Fachbücher, Tagungsbeiträge, Artikel, Poster und Patente unserer Mitarbeiterinnen und Mitarbeiter ab dem Jahr 2019. Publikationen vor 2019 finden Sie auf den entsprechenden Arbeitsgruppenwebseiten.
Autoren | Jahr | Titel |
|---|---|---|
| Monica Vergara-Araya, Leonie Echard, Felix Pilz, Henning Oeltze | 2024 | Energieeffizienz auf Kläranlagen: Regelwerke und Simulation KA Korrespondenz Abwasser, Abfall, 2024 (71) Nr. 2 |
Robert Heuer, Patrick Hellwig, Irena Maus, Daniel Walke, Andreas Schlüter, Julia Hossa, Alexander Scyrba, Tom Tubbesing, Michael Klocke, Torsten Mächtig, Kay Scvhallert, Ingolf Seick, Udo Reichl, Dirk Benndorf | 2024 |
Breakdown of hardly degradable carbohydrates (Lignocellulose) in a two-stage anaerobic digestion plant is favored in the main fermenter Water research, Volume 2450, 15. February 2024, 121020 |
Irene Slavik, Thomas Sebastian Bechle, Wolfgang Uhl | 2024 | Practical implications of adding powdered activated carbon in advanced wastewater treatment for process and plant design |
Petra Schneider, Timo Fauk, Florin-Constantin Mihai, Harald Junker, Bernd Ettmer and Volker Lüderitz | 2024 | Natural Climate Protection through Peatland Rewetting A Future for the Rathsbruch Peatland in Germany; Land 2024, 13, 581; https://doi.org/10.3390/land/3050581; pdf |
Irene Slavik, Thomas Sebastian Bechle, Wolfgang Uhl | 2023 | Einfluss von Pulveraktivkohle-Dosierungen auf die Aufbereitungsleistung der |
Ingolf Seick, Jürgen Wiese | 2023 | ThermoFlexWave Weiterentwicklung und Validierung einer Technologie zur internen Wärmespeicherung für eine effizientere Wärmenutzung von Biogasanlagen. In: Fokusheft Energetische Biogasnutzung 2023; Focus On Bioenergie im Strom- und Wärmemarkt, Projektergebnisse 2021-2022; S.27-30 |
| Julia Marie Zigann, Richard M. Gersberg and Volker Lüderitz | 2023 | Effects of Deadwood on Macroinvertebrate assemblages in Three Sand-Type Lowlands Streams; ecologies 2023, 4, 88-105; https://doi.org/10.3390/ecologies4010008 pdf |
Michael Seidel, Fengqing Li, Coroline Winking, Mario Sommerhäuser, and Volker Lüderitz | 2022 | Should We Sample more than Required by the European Water Framework Directive? Case study: Emscher Catchmant; Clean-Soil, Air, Water 2022, 2000391 (10S); www.advancedsciencenews.com pdf |
Rifo, C., Arriagada, P., Ettmer, B., Link, O. | 2022 | "Frequency analysis of extreme scour depths at bridge piers and their contribution to bridge collapse risk", Hydrological Sciences Journal, Taylor&Francis online, 17 Oct. 2022, https://doi.org/10.1080/02626667.2022.2122718 |
Pizarro, A., Ettmer, B., Link, O. | 2022 | "Relative importance of parameters controlling scour at bridge piers using the new toolbox ScourAPP", Computers & Geosciences 163 (2022) 105117, Elsevier, www.elsevier.com/locate/cageo, https://doi.org/10.1016/j.cageo.2022.105117 |
Ettmer, B., Hesse, D., Müller, S. | 2022 | "Morphologische Entwicklung der Alten Elbe bei Magdeburg. Entwicklungsstrategien und Maßnahmenoptionen", BAW-Kolloquium, Flussbauliche Herausforderungen an der Elbe im Wandel der Zeit, Tagungsband, Oktober 2022 |
Müller-Czygan, G.: Wiese, J.; Tarasynk,V. & Tschepetzki, R. | 2022 | Energieeinsparung auf Kläranlagen mit fallbasierter Steuerung (Case Based Reasoning)". In: Daniel Demmler, Detlef Krupka, Hannes Federrath (Hrsg.) "INFORMATIK 2022-Informatik in den Naturwissenschaften" (Tagung 26. bis 30.September 2022, Hamburg).S.1447-1472, DOI:10.18420/in2022_125 (Vortrag und Publikation) https://informatik2022.gi.de/programm/2022-09-28-1-1 (PROCEEDINGS DER INFORMATIK 2022) |
Vergara-Araya, M.; Oeltze, H.; Radeva, J.; Roth, A.G.; Göbbert, C.; Niestroj-Pahl, R.; Dähne, L.; Wiese, J. | 2022 | Operation of Hybrid Membranes for the Removal of Pharmaceuticals and Pollutants from Water and Wastewater. Membranes 2022, 12, 502. https://doi.org/10.3390/membranes12050502 |
Vergara-Araya, M.; Hilgenfeldt, V.; Steinmetz, H.; Wiese, J. | 2022 | Combining Shift to Biogas Production in a Large WWTP in China with Optimisation of Nitrogen Removal. Energies 2022, 15, 2710. https://doi.org/10.3390/en15082710 |
Seick I, Vergara-Araya M., Wiese J. | 2022 | Model-Based Analysis to Increase the Substrate Efficiency of a Biogas Plant. Chem. Eng. Technol. 2022, 45, No. 00, 1–12 https://onlinelibrary.wiley.com/doi/epdf/10.1002/ceat.202100370 |
| Anne Linn Ahlers, Lisa Siebeneichner, Uta Langheinrich und Volker Lüderitz | 2021 | Revitalisierung kleinerer Fließgewässer in Sachsen-Anhalt - Konformität statt Individualität; Wasserwirtschaft 11-2021; S.57-64; www.springerprofessional.de/wawi pdf |
| Katja Westphal, Michael Seidel und Volker Lüderitz | 2021 | Einfluss des übersaissonalen Niedrigwasserereignisses 2028/19 auf die Bewertungskomponente Makrozoobenthos in Fließgewässern Sachsen-Anhalts; WasserWirtschaft 11-21, 26-31 ; www.springerprofessional.de/wawi; pdf |
Núñez-González, F., Hesse, D., Ettmer, B., Gutiérrez, R. R, Link, O. | 2021 | "Development and validation of a novel metric for describing the threedimensionality of bed forms ", Geomorphology, Volume 390, 1 October 2021, 107856Geomorphology, ISSN: 0169-555X, https://doi.org/10.1016/j.geomorph.2021.107856, www.elsevier.com/locate/geomorph |
| Michael Seidel, Fengquing Li, Uta Langheinrich, Richard m. Gersberg, Volker Lüderitz | ||
Seidel, M., Ettmer, B., Lüderitz, V. | 2021 | "Mehr als nur Fischaufstieg: Die Sohlgleite in der Hase bei Quakenbrück und ihre Wirkung als Lebensraum", Korrespondenz Wasserwirtschaft 2021 (14) Nr. 6, S. 359 -368, www.dwa.de/KW, DOI: 10.3243/kwe2021.06.002 |
Ettmer, B., Hentschel, B. | 2021 | "Neue Wege in der Morphodynamik im wasserbaulichen Versuchswesen", Editorial, WasserWirtschaft 5-2021, S. 3, http://www.springerprofessional.de/wawi |
Hentschel, B., Ettmer, B. | 2021 | "Wasserbauliches Versuchswesen im 21. Jahrhundert", WasserWirtschaft 5-2021, S. 10-15, http://www.springerprofessional.de/wawi |
Ettmer, B., Hentschel, B., Link, O. | 2021 | "Neue Wege in der experimentellen morphodynamischen Modellierung durch die Verwendung von Kunststoffgranulat-Sieblinien", WasserWirtschaft 5-2021, S. 16-22, http://www.springerprofessional.de/wawi |
Link, O., Araneda, A., Flores, J., Rivas-Medina, A., Tinapp, F. Ettmer, B. | 2021 | "Stauraumverlandung von Hochgebirgstauseen: Experimentelle Modellversuche mit Mischungen aus Kunststoffgranulat und Sand", WasserWirtschaft 5-2021, S. 39-44, http://www.springerprofessional.de/wawi |
Müller, F., Ettmer, B., Link. O. | 2021 | "Kolke an Brückenpfeilern unter Sedimenttransportbedingungen mit Polystyrolgranulat" WasserWirtschaft 5-2021, S. 45-51, http://www.springerprofessional.de/wawi |
Ettmer, B., Alvarado Ancieta, C., Bleck, M., Broich, K., Gries, F., Link, O., Meyering, H., Pfleger, F., Schmidt, E., Stahlmann, A., Unger, J., Weichert, R., Werth, K., Zanke, U. | 2021 | DWA-Regelwerk, Merkblatt DWA M-529, "Auskolkungen an pfahlartigen Bauwerksgründungen", , 3-2021, Deutsche Vereinigung für Wasserwirtschaft, Abwasser und Abfall e.V., Bad Hennef, ISBN: 978-3-96862-066-4, www.dwa.de |
Müller-Czygan G., Wiese J., Fischer R., Zenke R., Frese A., Frigger M. | 2021 | Innovative Steuerung und Energiemonitoring sichert effizienten Kläranlagenbetrieb, auch während Pandemiezeiten. Fachbericht Abwasserbehandlung. gwf Wasser + Abwasser, 27.11.2021 |
Vergara-Araya, M.; Hilgenfeldt, V.; Peng, D.; Steinmetz, H.; Wiese, J. | 2021 | Modelling to Lower Energy Consumption in a Large WWTP in China While Optimising Nitrogen Removal. Energies 2021, 14, 5826. https://doi.org/10.3390/en14185826 |
| 2021 | Integrated Cycles for Urban Biomass as a Strategy to Promote a CO2-Neutral Society — A Feasibility Study. Journal Sustainability 2021, 13, 9505 |
I. Slavik, D. Kostrowski, W. Uhl | 2021 | Effect of solar radiation on natural organic matter composition in surface waters and resulting impacts on drinking water treatment |
Verena Hilgenfeldt, Heidrun Steinmetz, Di Peng, Joachim Clemens, Jianbin Guo, Mónica Vergara-Araya, Jürgen Wiese, Xuefei Zhou | 2020 | PIRAT-Systems: Energy- and Resource-Efficient Wastewater Treatment Processes for China. Econet-Monitor Green Markets & Climate change (December 2020). Online: |
Neumann K., Gerke G. | 2020 | Internationale Abfall- und Wasserwirtschaft: Erfahrungen einer deutsch-kubanischen Kooperation im Hochschulbereich. Müll und Abfall 8 (2020). DOI: https://doi.org/10.37307/j.1863-9763.2020.08.05 |
Fuss M., Vergara-Araya M., Barros R. T.V., Poganietz W.-R. | 2020 | Implementing mechanical biological treatment in an emerging waste management system predominated by waste pickers: A Brazilian case study. Resources, Conservation & Recycling 162 (2020) DOI: https://doi.org/10.1016/j.resconrec.2020.105031 |
Vergara-Araya M., Lehn H., Poganietz W.-R. | 2020 | Integrated water, waste and energy management systems – A case study from Curauma, Chile, Resources, Conservation & Recycling 156 (2020) 104725. DOI: https://doi.org/10.1016/j.resconrec.2020.104725 |
Bernd Ettmer, Linda Bromberg, Stefan Orlik, Klaus-Jürgen Steinhof, Clemens Löbnitz, Heiko Warnecke, Volker Thiele | 2019 | Hydraulische Berechnungen für die Entwicklung eines Auenstrukturplans an der Elbe in Niedersachsen, Wasserwirtschaft 11-2019, 72-76, http://www.springerprofessional.de/wawi |
| Michael Seidel, Fengqing Li, Uta Langheinrich, Volker Lüderitz | 2019 | Bioindikatorische Typisierung der Anbindung von Altgewässern der Mittelelbe; Wasserwirtschaft 11-2019,47- 53; www.springerprofessional.de/wawi pdf |
| Sabine Radke und Volker Lüderitz | 2019 | Wie wird Altwasserrevitalisierung für fische erfolgreich?; Wasserwirtschaft 11-2019,36- 41; www.springerprofessional.de/wawi ; pdf |
| Sabine Radke, Uta Langheinrich, Richard M. Gersberg and Volker Lüderitz | Reconnection and restoration of oxbow lakes - crucial factors for success; Wiederanbindung und Revitalisierung von Altwässern - entscheidende Faktoren für den Erfolg; Waldökologie, Landschaftsforschung und Naturschutz, online preview pdf |
Veröffentlichungen Auswahl bis 2016 bis 2020
| Autoren | Jahr | Titel |
|---|---|---|
| Verena Hilgenfeldt, Heidrun Steinmetz, Di Peng, Joachim Clemens, Jianbin Guo, Mónica Vergara-Araya, Jürgen Wiese, Xuefei Zhou | 2020 | PIRAT-Systems: Energy- and Resource-Efficient Wastewater Treatment Processes for China. Econet-Monitor Green Markets & Climate change (December 2020). Online: https://china.ahk.de/de/news/news-details/neueste-englisch-chinesische-ausgabe-des-econet-monitor-dezember-2020 |
| Neumann K., Gerke G. | 2020 | Internationale Abfall- und Wasserwirtschaft: Erfahrungen einer deutsch-kubanischen Kooperation im Hochschulbereich. Müll und Abfall 8 (2020). DOI: https://doi.org/10.37307/j.1863-9763.2020.08.05 |
| Fuss M., Vergara-Araya M., Barros R. T.V., Poganietz W.-R. | 2020 | Implementing mechanical biological treatment in an emerging waste management system predominated by waste pickers: A Brazilian case study. Resources, Conservation & Recycling 162 (2020) DOI: https://doi.org/10.1016/j.resconrec.2020.105031 |
| Vergara-Araya M., Lehn H., Poganietz W.-R. | 2020 | Integrated water, waste and energy management systems – A case study from Curauma, Chile, Resources, Conservation & Recycling 156 (2020) 104725. DOI: https://doi.org/10.1016/j.resconrec.2020.104725 |
| Seick, I.; Vergara-Araya M.; Wiese, J. | 2018 | ThermoFlex: Heat Storage in Secondary Digesters for Flexible Power Generation of Biogas Plants. In: Chem. Eng. Technol. 41 (11), S. 2132–2140. DOI: https://doi.org/10.1002/ceat.201800153 |
| Wiese, J.; Seick, I. | 2018 | Optimierung von Kläranlagen und Biogasanlagen durch Mess- und Automationstechnik sowie Computersimulation, WasserWirtschaft, Heft 1/2018, S. 39-44, Springer Vieweg-Verlag, Wiesbaden |
| Seick, I.; Wiese, J. | 2017 | ThermoFlex - Nachgärer als Wärmespeicher für flexible Biogasanlagen. Eingereicht und angenommen für: 7. Statuskonferenz „Bioenergie. Flexibel und integriert in die nächste Epoche!“ am 20.-21. November 2017, Leipzig |
| L. Weitze, H. Schröder, J. Wiese | 2017 | Biogas Plant 4.0 – Opportunities and requirements for existing facilities. Progress in Biogas IV, International Conference organised by IBBK and University of Hohenheim, Stuttgart, Germany |
| Seick, I.; Wiese, J. | 2017 | ThermoFlex - Flexible Wärmebereitstellung durch Biogasanlagen. 11. Rostocker Bioenergieforum 22.-23.06.2017. In: Schriftenreihe Umweltingenieurwesen, Agrar- und Umweltwissenschaftliche Fakultät, Band 68. Hrsg.: M. Nelles, Universität Rostock. |
| Wiese, J., Cuhls, C., Seick, I. | 2016 | State and potential of anaerobic biowaste treatment in Germany. Narossa 20th International Conference for Renewable Resources and Plant Biotechnology (Tagungssband), Magdeburg |
| Seick, I. | 2016 | Projekt ThermoFlex: Thermophile Nachgärer als Wärmespeicher für flexible Biogasanlagen. 5. Gemeinschaftsveranstaltung Biogas, Biozentrum Halle, 29.09.2016, Deutschland |
| Wiese, J., Hilfenhaus, R. | 2016 | deen statt Beton: Kontinuierliche Optimierung der Kläranlage Neuenhaßlau. Modernisierungsreport 2016/2017,S.19-23,Huss Medien GmbH, Berlin |
| Poganietz, W.-R., Lehn, H., Vergara, M., Steiner, F. | 2016 | Separating wastewater at the source: Impacts on Energy efficiency in decentralized energy systems. Joint 12th Socio-Economic Metabolism Section Conference and 5th Asia-Pacific Conference. Nagoya, Japan, 28.-30.09.2016 |
| Thiel, P.; Neumann, K | 2016 | Ansätze zur Umweltbildung in der Region Gibara. Vortrag beim 1. Workshop Kompetenzzentrum, 8./9.März 2016 an der Universität Holguin. Holguin/ Kuba |
| Herrmann, J.; Neumann, K | 2016 | Optimierungsmöglichkeiten von Biogasanlagen: Vortrag beim 1. Workshop Kompetenzzentrum, 8./9.März 2016 an der Universität Holguin. Holguin/ Kuba |
Kontakt

Institutsdirektor
Prof. Dr.-Ing. habil. Jürgen Wiese
Tel.: (0391) 886 43 73
E-Mail: juergen.wiese@h2.de oder iwo@h2.de
Ort: Campus Magdeburg, Haus 6, Raum 2.12

Wissenschaftlicher Mitarbeiter
Henning Oeltze
Tel.: (0391) 886 43 19
E-Mail: henning.oeltze@h2.de
Ort: Campus Magdeburg, Haus 7, Raum 2.18
Kommende Veranstaltungen
Programm zur Eingliederung internationaler Akademiker in den deutschen Arbeitsmarkt
Projekt zur nachhaltigen Stabilisierung des Grundwasserhaushaltes
Am 3. Juli 2024 wurde an den Wasserverband Gardelegen der Fördermittelbescheid vom Minister übergeben. Die Arbeistgruppe von Prof. Wiese begleitet das 3-jährige Projekt wissenschaftlich.
Ziel ist es, möglichst übertragbare Lösungen für die Verwendung gereinigten Abwassers zur Stabiliserung des Grundwasserhaushaltes in der Region zur Sicherung der Wasserversorgung in der Zukunft zu finden.
Interdisziplinäres Projekt: SmartRegion
Das Projekt SmartRegion LSA fördert die nachhaltige und digitale Vernetzung Sachsen-Anhalts, um den strukturellen Wandel wachsender Städte und ländlicher Gebiete zu bewältigen. Es entwickelt Modelle für Energie, Wohnen, Wasser und Mobilität und optimiert durch ein Orchestrierungswerkzeug die Planung. Ziel ist ein digitales Lebensumfeld, mehr Lebensqualität und Akzeptanz smarter Technologien. Neben den oben genannten Forschungsschwerpunkten unserer Projektpartner, liegt der Teilbereich „Trinkwasser und Abwasser“ in unserem Verantwortungsbereich. Hierbei wird verstärkt auf die Herausforderungen des Klima- und Demografiewandels in Sachsen-Anhalt eingegangen. Die Steigerung der Energieeffizienz und die Nutzung von Energiepotentialen auf Kläranlagen oder Wasserwerken wird dabei eine der Hauptaufgabenstellungen. Erarbeitet werden Ansätze und Modelle zum gezielten Einsatz von Mess- und Automationstechnik auf diesen Wasserwirtschaftlichen Anlagen. Eine weitere große Herausforderung ist die Digitalisierung der für die Siedlungswasserwirtschaft relevanten Geobasisdaten. Durch eine gekonnte Zusammenführung von vorhandenen, aber teilweise unterschiedlichen Geobasisdaten, sollen Synergien der einzelnen Infrastrukturen aufgezeigt werden, sodass sektorübergreifende Planungen erleichtert werden.